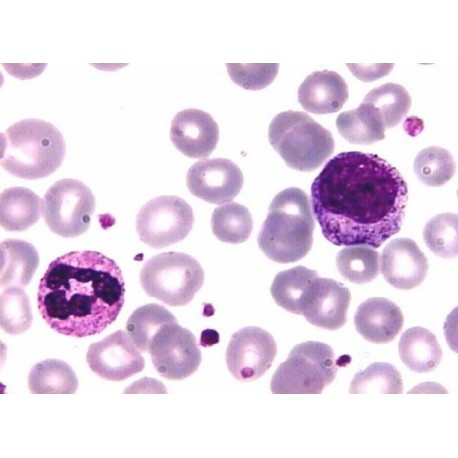
Tincion May-Grünwald 250ml

Referencia: B17090
Mesa 2 en 1, Consulta y Eco-Cardio 120x51cm. Altura 90cm
MESA 2 EN 1 , CONSULTA Y ECO-CARDIO FENÓLICO Y TABLERO INOXIDABLE Plano de 120 x 51 cm. Altura 90 cm
Referencia: B17090
MESA 2 EN 1 , CONSULTA Y ECO-CARDIO FENÓLICO Y TABLERO INOXIDABLE Plano de 120 x 51 cm. Altura 90 cm
Referencia: B15736
3M HOJAS DE PAPEL CREPE STERI-GREEN Pliego de 75x75 cm


Tinción panóptica hematológica May Grúnwald-Giemsa
Tinción panóptica hematológica May Grúnwald-Giemsa